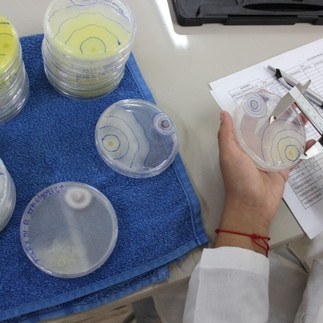

ESPOCH analizan la forma de disminuir químicos para el agro
- inforiocomunicacio
- 2 dic 2022
- 1 min de lectura
02 de diciembre de 2022

Chimborazo// ESPOCH estudia el Trichoderma Spp para disminuir el uso de químicos en producción agrícola.
Docentes de la Facultad de Recursos Naturales realizan el “Estudio de Trichoderma Spp. en viveros forestales de la provincia de Chimborazo y suelos agrícolas en Santa Cruz, Islas Galápagos” con la finalidad de reducir el uso de productos químicos en los suelos agrícolas.
Investigadores politécnicos que integran la Unidad de Estudios Fito Entomológicos (UEFE) estudian el Trichoderma Spp., un hongo anaeróbico habitante natural del suelo que por sus características puede servir como agentes de control de hongos fitopatógenos, evitando la utilización de productos químicos que afecten a microorganismos benéficos para la producción agrícola.
Durante la investigación se han analizado muestras de alrededor de 25 sitios en la provincia de Chimborazo y siete sitios en Santa Cruz, Galápagos, lo que permite aislar alrededor de 40 cepas en el continente y 20 procedentes del archipiélago.
Además, se han realizado cinco ensayos a nivel de vivero para determinar y seleccionar aislados con potencial biocontrolador. 15 ensayos para probar el efecto bioestimulante y germinativo de diferentes cepas de Trichoderma, tanto de Chimborazo como de Santa Cruz.
El propósito final de este proyecto es determinar la eficiencia del Trichoderma Spp., a nivel de laboratorio y campo, para promover su utilización en las actividades que realizan productores, viveristas y personas vinculadas a la agronomía.

Comentarios